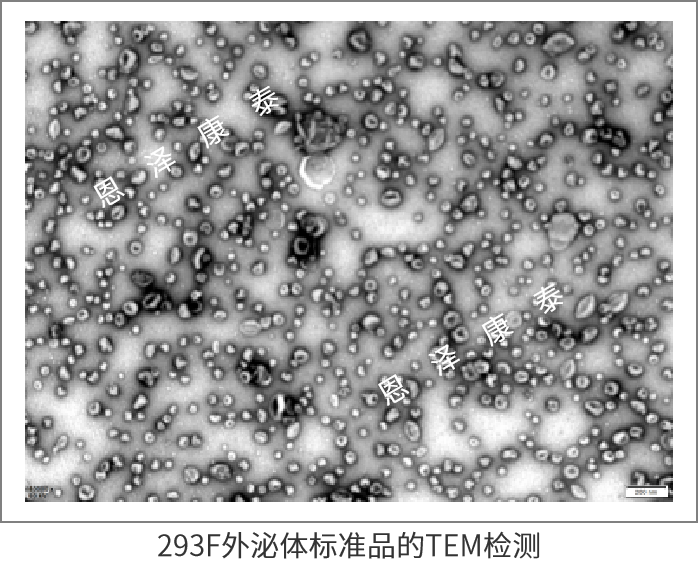

293F外泌体标准品是由来源清晰的HEK293F细胞,通过无血清培养获得上清液后,经切向流超滤(TFF)、密度梯度离心(DGC)分离纯化获得的超高纯度外泌体颗粒,可用于外泌体表征标准品或对照品等。
293F外泌体标准品是由来源清晰的HEK293F细胞,通过无血清培养获得上清液后,经切向流超滤(TFF)、密度梯度离心(DGC)分离纯化获得的超高纯度外泌体颗粒,可用于外泌体表征标准品或对照品等。
| 产品 | 货号 | 规格 |
| 293F外泌体标准品 | CTE-062 | 3E+10 Particles/100μL |
用于外泌体表征的标准品或对照品。
经测试只要不是手残党、或者实验SOP有问题,用ContrExo®外泌体标准品CTE-062做电镜、粒径和WB表征,都能有一个比较好的结果,所以ContrExo® CTE-062外泌体标准品可用于作为外泌体表征实验的阳参以对实验流程进行质控,不限于电镜、粒径、WB三阳一阴表征。
其他的表征比如CD9/CD81/CD63阳性率检测的阳参、HLPC-SEC纯度检测的阳参、膜完整性检测的阳参等均可。
1)现货无忧购,即买即用:无须繁琐费时的细胞培养,不用思考用什么方法分离大体积上清来源外泌体,也不用耗时费心去做几升以上大体积上清分离纯化实验,更无须发愁如何做外泌体品控。
2)标准9项质控,成就“试金石”品质:外观、pH、无菌检测、颗粒浓度、颗粒粒径分布、总蛋白浓度、纯度、TEM形态检测、外泌体蛋白标志物WB检测;
编号 | 参数项 | 参数结果 |
1 | 外观 | 透明液体 |
2 | pH | 6.8-7.4 |
3 | 无菌检测 | 阴性 |
4 | 颗粒浓度 | ≥3E+11 Particles/ml |
5 | 颗粒粒径分布 | 30-150 nm |
6 | 总蛋白浓度 | ≤10.0 µg/µL(BCA) |
7 | 纯度 | ≥5E+11 Particles/mg |
8 | 形态检测 | 清晰的囊泡结构(TEM) |
9 | 外泌体蛋白标志物 | 3阳1阴(WB) |
3)超高纯度:经由TFF+密度梯度离心,纯度(Particles/Protein比值)保证≥5E+11 Particles/mg。
4)高安全性:从细胞培养、上清收获到外泌体纯化进行全流程的品控。全程生产环境:C+A;无血清培养体系(不含动物源成分);经过无菌等安全性质控合格。
粒径分布表征

TEM电镜表征
三阳一阴WB表征

Q:每批产品都会做标准的表征鉴定吗?
A:每批产品会做标准鉴定,但客户用于发文章时需要单独做一套表征结果图。
Q:该产品是冻存还是干粉?
A:该产品目前仅有冻存形式,干冰运输,收到产品后请于-80℃保存。
Q:该产品有什么特殊需注明的地方吗?
A:首先,我们的外泌体是加了药用辅料配方buffer,用于保存,使外泌体可以更稳定存在;另外,由于外泌体的特性,会随着冻存时间延长颗粒数下降,目前我们测试数据显示冻存-80℃保存1年颗粒数下降量为10-30%,收到产品后请尽快使用;此外,所有外泌体建议尽量避免反复冻融。
Q:加了药用辅料配方buffer后,会有什么影响吗?
A:我们的药用辅料配方buffer是外泌体的保护剂,可提高外泌体保存的稳定性,对外泌体本身无影响,但会影响总蛋白浓度检测(BCA),建议采用颗粒数作为定量方式,或者直接使用出厂蛋白浓度结果。若需重新定量,需将样品用磷酸盐缓冲液(PBS)等实验室常规缓冲液进行换液,再进行蛋白浓度测定,这种方法损失率比较大,不建议。
Q:1支CTE-062外泌体标准品才100μl,能满足电镜、粒径和WB三阳一阴表征实验的需求吗?
A:可以的。别看CTE-062体积小,BCA浓度低(0.1μg/ml左右 ),但是颗粒浓度高(≥3E+11 Particles/ml),纯度高啊,纯度越高杂蛋白含量越低。一般基础表征比较费样本的是WB,每个蛋白建议您上样10-15μl CTE-062外泌体标准品进行WB实验。
1、A Label-Free Liquid Chromatography–Tandem Mass Spectrometry Method for the Quantitative Analysis of Exosome Pharmacokinetics In Vivo,Pharmaceutics, 2025 IF=5.5 https://www.mdpi.com/1999-4923/17/6/699
